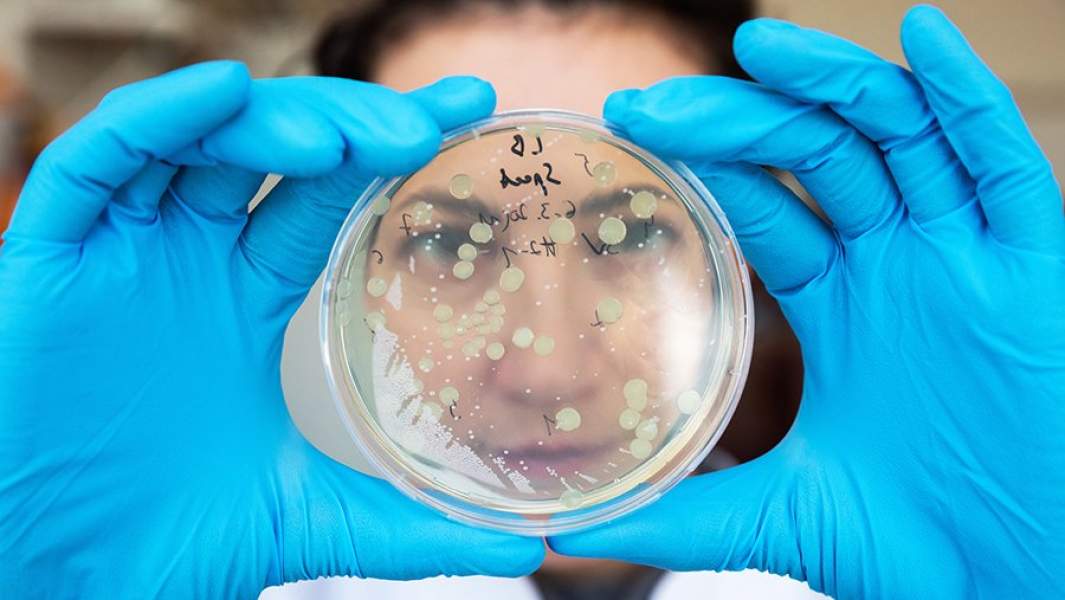
генетика

Зов генов: в России появится единая сеть биоресурсных центров

Развитие генетических технологий играет важнейшую роль для страны. В частности, Россия должна обладать целой линейкой разработок, позволяющих лечить тяжелые заболевания и увеличивать продолжительность жизни человека, а также улучшать состояние окружающей среды. Об этом президент заявил во время совещания о развитии генетических технологий в РФ, которое прошло 14 мая в режиме видеоконференции. Владимир Путин также призвал уделить внимание выстраиванию современной системы подготовки кадров и модернизации отечественной приборной базы, которая позволит ученым проводить исследования на мировом уровне. По мнению главы государства, в России необходимо создать единую сеть биоресурсных центров.
Практические результаты
Развитие генетических технологий остается одним из приоритетов для государства. При этом в условиях пандемии новые разработки и вовсе становятся жизненно важным вопросом. Сегодня именно генетические исследования помогают прокладывать путь к созданию тест-систем, вакцин и лекарств, в том числе и от COVID-19, напомнил Владимир Путин в начале совещания.
Тем не менее, совершенствование генетических технологий имеет более широкое применение. По словам президента, «Россия должна обладать целой линейкой разработок, которые позволят предупреждать и лечить тяжелые заболевания, увеличивать продолжительность жизни людей, состояние окружающей среды, очищать от загрязнений землю, воду, воздух, применять экологически чистое биотопливо».
— То есть речь идёт о самых разных областях — от медицины и сельского хозяйства до промышленности и энергетики, где генетические технологии открывают колоссальные возможности, — подчеркнул глава государства.
По мнению Владимира Путина, по значимости программа развития генетических технологий сопоставима с атомным и космическим проектами ХХ века. Поэтому сейчас важно не просто создать научные заделы, а «конвертировать их, и причем как можно быстрее, в практические результаты, в реальные технологии, конкурентную — и в России, и в мире — продукцию», подчеркнул он.
Для этого, в частности, по линии национального проекта «Наука» созданы три геномных центра по четырем основным направлениям: биобезопасность, медицина, сельское хозяйство и промышленность. В качестве головной организации выступает Национальный исследовательский центр «Курчатовский институт».
По словам вице-премьера Татьяны Голиковой, уже удалось добиться конкретных результатов. В частности, речь идет о центре, который работает на базе головной организации.
— Этим центром в 2019 году были проведены работы по созданию штаммов бактерий, производящих метаболиты и ферменты, которые применяются в сельском хозяйстве в качестве кормовых добавок для животных, а также разработаны отдельные направления, касающиеся модификации геномов бактерий, которые вырабатывают различные аминокислоты, они перспективны в использовании в сельском хозяйстве, — пояснила она.
Главным технологическим партнером проекта по созданию геномных центров стала «Роснефть». Ее глава Игорь Сечин во время совещания попросил президента исключить инвестиции компании в генетические исследования из расчета налогооблагаемой базы.
Привлечь специалистов
На встрече слово было предоставлено и главам ведущих научных организаций. Так, директор Национального исследовательского центра «Курчатовский институт» Александр Благов предложил открыть Национальный биоресурсный центр оцифровки и хранения генетических данных.
— Сейчас уже в рамках Курчатовского геномного центра мы приступили к созданию модели, прототипа такого биоресурсного центра. Но, конечно, без поддержки государства мы не сможем это сделать быстро и в необходимых масштабах, — сказал он.
Согласно плану Нацпроекта «Наука», а также федеральной научно-технической программы развития генетических технологий до 2027 года Россия должна избавиться от критической зависимости науки от иностранных баз генетических и биологических данных, программного обеспечения и приборов, иметь своих мышей и других животных для моделирования заболеваний человека, обеспечить поддержание коллекций микроорганизмов, а также пополнение обширных биоинформатических баз данных.
Это основа любой деятельности, связанной с обеспечением биобезопасности, созданием новых лекарств, повышения урожаев и наращивания темпов производства в животноводческих хозяйствах.
Для этого уже сейчас создана биогенетическая сеть из трех центров мирового уровня, объединивших ведущие научные организации России. Один из этих центров работает на базе Курчатовского института.
— За первый год реализации программы уже созданы ключевые элементы этой сети, — рассказал в ходе видеоконференции с Владимиром Путиным Александр Благов. — Три геномных центра мирового уровня, которые, по сути, охватывают все направления программы. Центры представляют собой консорциумы ведущих в области генетических исследований организаций Российской Федерации, всего 15 организаций.
Каждому из этих трех центров правительство обещало выделить около 3,7 млрд рублей. Однако, финансирование должно идти по разным направлениям, что позволит создать благоприятные условия для возвращения в Россию соотечественников — ученых мирового уровня, считает руководитель Научно-образовательного центра геномных исследований СФУ, профессор Гёттингенского университета (Германия) Константин Крутовский.
— За последние годы много сделано для привлечения уехавших из России ученых-генетиков к работе в экспертных советах и совместных научных проектах. Были созданы программы мегагрантов, проект «5-100», специальные программы РНФ и РФФИ. Но этого недостаточно. Надо создать более благоприятные условия для привлечения зарубежных ученых мирового уровня для переезда и постоянной работы в России. Для этого нужны сопоставимо оплачиваемые и постоянные позиции в университетах по всей стране, — сказал он «Известиям».
По мнению ученого, пандемия коронавируса особенно ярко продемонстрировала важность геномных исследований для создания быстрых и надежных тестов и эффективных вакцин.
От спорта к культуре
Между тем гендиректор государственного научного центра «Вектор» Ринат Максютов сообщил о планах в скором времени зарегистрировать вакцину от COVID-19.
— Очень рассчитываю на то, что ваша работа будет завершена в те сроки, о которых вы сейчас сказали, что регистрация этой вакцины против коронавируса будет осуществлена в сентябре. Интеллектуальная собственность только, подумайте об этом заблаговременно, должна быть, безусловно, обеспечена, — отреагировал Владимир Путин.
Кроме того, во время совещания стало известно, что «Вектор» совместно с компанией «Биокад» уже осенью планируют начать второй и третий этапы испытания уникальной вакцины против натуральной оспы.
Видеоконференция не обошлась и без обсуждения спорта. Так, директор ФГБУН «Институт молекулярной биологии имени В.А. Энгельгардта РАН» Александр Макаров рассказал, что ученным удалось установить генетические особенности биатлониста Евгения Устюгова, который был раннее дисквалифицирован за нарушение антидопинговых правил.
— В трех генах, наиболее важных и ассоциированных с повышением содержания гемоглобина, были выявлены крайне редкие мутации, определяющие, естественно, повышенный уровень гемоглобина, — подчеркнул Александр Макаров, добавив, что эту информацию используют юристы при оспаривании обвинений в Спортивном арбитражном суде.
От спорта Александр Макаров перешел к области культуры, рассказав президенту о состоянии актрисы Анастасии Заворотнюк. По его словам, ученые подобрали вирусы, которые смогут бороться с клетками опухоли.
— Но пока там ситуация не настолько тревожная, чтобы применять нашу технологию, — констатировал Александр Макаров.
Подводя итоги, президент, в первую очередь, призвал выстроить современную систему подготовки кадров, которая позволит развивать генетические технологии. Кроме того, глава государства предложил запустить учебные курсы и отдельные модули по генетике для школ, а также учреждений дополнительного образования. Важно уделить внимание и повышению квалификации педагогов, уверен он.
Российский лидер также ожидает от кабмина конкретных предложений по созданию отечественной приборной базы, которая предоставит возможность ученым проводить исследования в области генетики на мировом уровне. Президент согласился и с необходимостью создать Национальную базу генетической информации с помощью средств федерального бюджета.
— Речь о том, чтобы на основе единых стандартов обеспечить защиту данных, их хранение и передачу, разработку программных средств поиска, анализа и моделирования информации, — заявил он.
Глава государства также считает необходимым объединить научные коллекции отечественных институтов в единую сеть биоресурсных центров.
— Так, всему миру известна коллекция семян и растений Всероссийского института растениеводства, которую Николай Иванович Вавилов начал создавать ещё в 20-х годах прошлого века. Нужно сберечь, систематизировать, обобщить это, без всякого преувеличения, богатство, достояние нашей страны, — подчеркнул Владимир Путин.
Президент обратил внимание на огромную силу генетических технологий. Он призвал выстроить систему контроля за их использованием, а также найти баланс между свободой научного поиска, технологического развития, защитой интересов людей и вопросами этики.